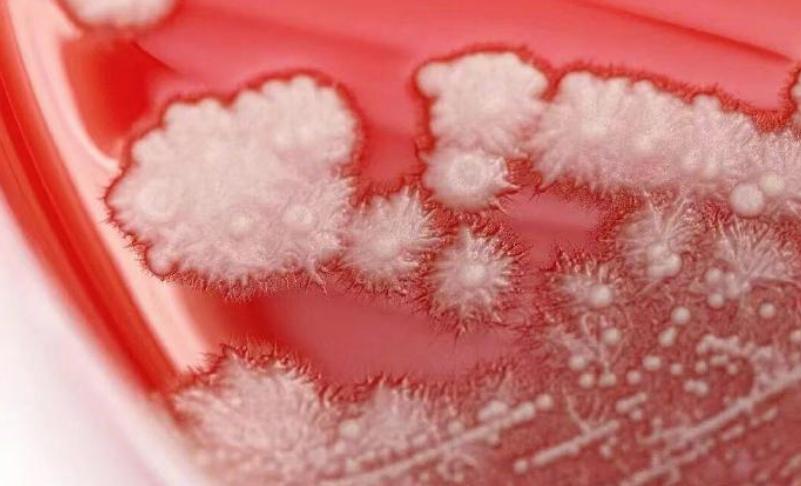

浙江宁波,男子发现喉咙疼,当时就觉得自己可能受风感冒了,也没有太在意,可一个月的时间过去了,症状不但没有缓解,反而越来越严重,去医院检查后被医生告知喉咙真菌感染,而这和他吃抗生素消炎有关 张先生今年36岁,做销售工作,平时忙得连轴转,熬夜加班、频繁出差是家常便饭。一个月前,他忽然觉得喉咙有点疼,心想大概是普通感冒,也没多在意,顺手从家里药箱翻出常备的抗生素,吃了几颗打算“压一压” 没想到,这一压,不但没压住,反而把问题压严重了。喉咙痛不但没好转,还越来越厉害,拖了一个月后,他终于去了医院。医生用喉镜一看,他整个喉咙后壁覆盖着一层白茫茫的东西,像落了一层雪,这是典型的真菌感染迹象 检查结果证实,张先生得的不是普通咽喉炎,而是“真菌性咽喉炎”,病原体是白色念珠菌。这种菌本来就存在于大多数人的口腔里,平时相安无事,可一旦人体免疫力下降,或是口腔菌群失衡,它就会趁机大量繁殖 医生分析,张先生长期工作压力大、作息不规律,免疫力已经打了折扣;再加上一不舒服就习惯性吃抗生素,虽然能杀死一部分致病细菌,但同时也误伤了口腔里很多有益的菌群 简单来说,抗生素是用来对付细菌的,可它没分好坏,把口腔和咽喉里的正常菌群也一并“清场”,好菌没了,白色念珠菌就趁机上位。再加上他本身长期熬夜、压力大、免疫力低,就成了真菌滋生的温床 这其实就是一个生活中的误区,抗生素不是“消炎万能药”。很多人喉咙一痛、感冒发烧,第一反应就是“吃点抗生素消消炎”。但抗生素只对细菌感染有用,对病毒、真菌都没效果 张先生这次算是给大家提了个醒。身体出了问题,别动不动就靠自己“瞎调理”。咽喉痛可能是细菌,也可能是病毒或真菌引起的,症状看起来差不多,但治疗完全不同